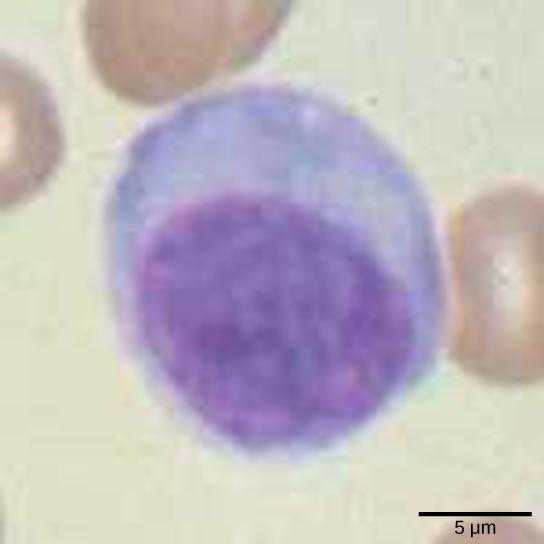
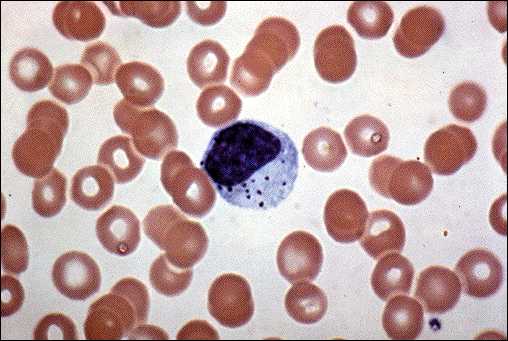

Иммунная система — Википедия
Материал из Википедии — свободной энциклопедии

Имму́нная систе́ма — система органов, существующая у позвоночных животных и объединяющая органы и ткани, которые защищают организм от заболеваний, идентифицируя и уничтожая опухолевые клетки и патогены. Иммунная система распознаёт множество разнообразных возбудителей — от вирусов до паразитических червей — и отличает их от биомолекул собственных клеток. Распознавание возбудителей усложняется их адаптацией и эволюционным развитием новых методов успешного инфицирования организма-хозяина.
Конечной целью иммунной системы является уничтожение чужеродного агента, которым может оказаться болезнетворный микроорганизм, инородное тело, ядовитое вещество или переродившаяся клетка самого организма. Этим достигается биологическая индивидуальность организма.
В иммунной системе развитых организмов существует множество способов обнаружения и удаления чужеродных агентов: этот процесс называется иммунным ответом. Все формы иммунного ответа можно разделить на врождённые и приобретённые реакции. Основное различие между ними в том, что приобретённый иммунитет высокоспецифичен по отношению к конкретному типу антигенов и позволяет быстрее и эффективнее уничтожать их при повторном столкновении. Антигенами называют молекулы, воспринимаемые как чужеродные агенты и вызывающие специфические реакции организма. Например, у перенёсших ветрянку, корь, дифтерию людей часто возникает пожизненный иммунитет к этим заболеваниям. В случае аутоиммунных реакций антигеном может служить молекула, произведённая самим организмом.
Некоторые вещества, вырабатываемые иммунной системой, активно влияют на работу центральной нервной системы[1].
ru.wikipedia.org
Основные клетки иммунной системы человека
Иммунная система обеспечивает человека здоровьем и активной жизнедеятельностью. Самым важным звеном в комплексной защите являются клетки иммунной системы.Иммунная система
Иммунная система — это защитные механизмы и реакции по предоставлению организму устойчивости и сопротивляемости к негативным факторам внешней и внутренней среды.

Иммунитет представлен рядом органов, которые синтезируют, распространяют и влияют на функционирование иммунокомпетентных клеток:
- Периферических — печень, селезенка, лимфатические узлы, миндалины;
- Центральных — вилочковая железа, тимус.
Иммунная система подразделяется на виды:
- Врожденный — наличие генетически обусловленной защиты;
- Приобретенной — развитие и усовершенствование механизмов и реакций.
Так как иммунитет выполняется на двух уровнях — гуморальном и клеточном, то можно выделить специфические и неспецифические виды защиты, которые зависят от вида иммунитета.
Так же совокупность деятельности врожденного и адаптационного иммунитетов определяет быстроту и эффективность наступления иммунного ответа.
Иммунный ответ — это реакция защитной системы на проникновение чужеродного объекта или изменение собственных клеток организма. Он состоит из двух циклов:
- Поиск и распознавание чужеродного гена;
- Координация всех иммунокомпетентных клеток на обезвреживание и уничтожение патогена.
При этом иммунитет имеет функции по запоминанию, то есть клетки естественно приобретенного вида способны формировать иммунологическую память для более эффективного и быстрого иммунного ответа на повторное заражение возбудителем.

Иммунокомпитентные клетки
Клетки иммунной системы представляют собой мезенхимы по происхождению, имеют единую родоначальную клетку стволового типа, образованную красным костным мозгом. Делятся на две основные категории. К первой категории относятся клетки иммунитета, имеющие специализированные функции:
- Популяция лимфоцитарных клеток;
- Группа дендринных клеток.
Ко второй категории относят клеточные тела акцессорного характера или вспомогательные:
- Популяция лейкоцитарных клеток;
- Клеточные эпителиальные тельца;
- Красные кровяные клетки;
- Тромбоциты;
- Сосудистые эндотелии.
Для каждой группы клеток характерны:
- Определенное место синтеза;
- Специализированная локализация по органам, тканям и системам;
- Биологический активный состав;
- Наличие или отсутствие собственных морфологических признаков.
Так же иммунные клетки можно поделить на типы:
- Зернистые гранулоциты — белые тельца, которые св своей цитоплазме имеют гранулы;
- Незернистые агранулоциты — белые кровяные тельца, не имеющие в своей структуре гранул, ядро не включает в себя какие-либо сегменты.

Клетки врожденного иммунитета
Врожденный иммунитет — это генетически заложенная защита организма.
Клеточные структуры всегда готовы защитить организм от определенных видов патогена, а так же обеспечивает барьерную функцию против патогенных и условно-патогенных микроорганизмов. Она осуществляется клеточными механизмами и реакциями одного типа, которые имеют идентичный набор рецепторов. Благодаря своим специфическим функциям клетки врожденного иммунитета активируют клеточные конструкции приобретенного.
Главными реакциями, действие которых обеспечено врожденными иммунными клетками, являются:
- Опсонизация — реакции, стимулирующие и облегчающие фагоцитоз;
- Фагоцитоз — процесс захватывания и переваривания патогеных частиц;
- Уничтожение патогена внутри клетки;
- Секреция цитокиновых компонентов.
Клеточная структура имеет разно видовую колонию лейкоцитов.

Нейтрофилы
Первое самое многочисленное звено защитных клеток представлено нейтрофилами. Их популяция составляет около семидесяти процентов от числа всех лейкоцитарных тел, при этом молодые нейтрофилы палочкоядерного типа — полтора процента, а остальные зрелые виды.
Нейтрофильные тельца — это полиморфоядерные гранулоцитарные представители лейкоцитов, имеющие ядро состоящее из сегментов. Они являются представителями фагоцитов. В осуществлении фагоцитарной функции действуют как микрофаги, и способны распознавать, прикрепляться и поглощать мелкие патогенные частицы. Закончив фагоцитоз, нейтрофилы погибают, производя дегрануляционные процессы и усиливая миграцию иммунных клеток в очаг инфекции.
Нейтрофилы выполняют иммунологические функции в борьбе с болезнетворными бактериями и грибками, принимают участие в противовирусном ответе, а в противопаразитарном и противоопухолевом иммунитете не участвуют.
Изменение уровня нейтрофилов в крови говорит о наступлении иммунных реакций на проникновение бактериальных и других инфекций, но при хронических заболеваниях их уровень остается в пределах нормы.

Эозинофилы
Еще одним видом врожденных иммунных агентов являются — эозинофильные клетки — это один из подвидов лейкоцитарных телец, имеющее в своей структуре ядро двудольчатого типа. По направленности эозинофилы не циркулирующие, они могут только проникать из кровотока в ткани и направляться в очаг пораженной области. Осуществляют процессы фагоцитоза и являются микрофагами. Основной функцией считается цитотоксическая, так же активно участвует в противопаразитарной защите организма, поглощают гистамин и разного рода медиаторы.
В анализе крови при тяжелых аллергических процессах повышается уровень эозинофилов.
Макрофаги
Клеточные структуры соединительно-тканной части организма, обладающие выраженными свойствами фагоцитарной функции и характеризуются продолжительной жизнедеятельностью называются макрофагами. По строению макрофаговые клетки отличаются в зависимости от свойства по поглощению патогенного элемента. В их структуре много митохондрий, гранул, ядра, как правило, неправильной формы. При начале фагоцита в макрофагах появляются лизосомы и фагосомы.
Основными функциями макрофагов являются:
- Особая переработка антигенных компонентов;
- Уничтожение патогена путем активирования ферментов и лизосомов;
- Участвуют в синтезе антител;
- Взаимодействуют в образовании иммунного ответа с лимфоцитами типа В и Т;
- Макрофаги синтезируют трансферины, составляющие системы комплимента, лизоцимы, интерфероны, пирогены, а так же другие антибактериальные вещества;
- Участвуют в образовании антибактериального и противовирусного иммунитетов;
- Макрофаговые тельца способствуют выведению и снижению скорости распространения инфекции, обеспечивая связь антитело-антиген;
- Поддерживает цитотоксическое действие лейкоцитарной системы против онкологии лимфицитной системы.

Моноциты
Крупные лейкоцитарные клетки мононуклеарныго типа — это моноциты. После их синтеза красным косным мозгом, они циркулируют по кровеносной системе не более сорока часов и уходят в тканевые сплетения, где становятся гистиоцитами соединительно-тканного аппарата, печеночными купферовскими телами, макрофагами альвиол, селезенки, костного мозга, лимфатической системы.
Для них характерны функциональные свойства:
- Выполняют фагоцитную функцию;
- Способствуют очищению очагового места воспаления и крови от антигенов;
- Синтезируют секреторные вещества и медиаторы;
- Способствуют росту фибропластов, белковых соединений комплимента;
- Создают условия для успешной регенерации тканей, после уничтожения патогена.
Эпителиальные клетки
Эпителиоциты — это основной структурный эпителиальной ткани, они разнообразной формы, в зависимости от функций имеют одно или несколько ядер. Могут быть однослойными и многослойными. Так как они выстилают поверхностные слои кожи, полости тела и органов, слизистые оболочки, характер свойств зависит от места расположения клеточных структур.
Главными функциями являются:
- В кожных покровах — барьерная и защитная;
- В кишечнике — всасывающая;
- В органах дыхания — эвакуаторная;
- В почках — всасывающая, экскректорная;
- В железистых эпителиях — синтез секреторных веществ.

Естественные киллеры
Натуральные киллеры — это лимфоцитные клетки, имеющие большие размеры.
Данный тип клеток обеспечивает защиту организма от опухолевых, мутировавших собственных клеток, а так же является частью противовирусной врожденной защиты.
Естественные киллерные тела имеют цитотоксическое свойства, участвуют в синтезе цитокинов. Благодаря наличию на поверхностной мембране специфических маркеров они предназначены для уничтожения патогенов, не имеющих признаков гистосовместимости первого класса.
Дендринные клетки
Антиген презентующие тела, формирующиеся костным мозгом, распространенные по всей лимфатической системе — это клетки дендринного типа. К ним относятся:
- Миелоидные тела способные захватывать и презентовать антиген, стимулируя деятельность Т-клеток;
- Плазмоцитоидные тела проводят синтез интерферона типа альфа и бета.
Основными функционалами клеток являются:
- Инициация и поддержание воспалительной реакции;
- Синтез цитокинов для активации деятельности Хелперов типа Т;
- Участвуют в регулировании иммунологических процессов;
- Активируют лимфоциты типа Т при первом контакте с патогеном;
- Являются участником практически всех иммунологических реакций на вторжение возбудителя.
Тучные клетки
Мастоциты и лаброциты — тучные клеточные тела, расположенные в соединительной ткани: на коже, в слизистых, в бронхах. Имеют очень небольшие размеры, на поверхности расположено огромное количество рецепторов, а внутри гранулы с активными ферментами и биологическими веществами. Главная их задача состоит в защите и сохранении внутреннего постоянства организма от внедрения патогенных объектов, создавая условия для их задержки в точке проникновения. При этом, активизируясь, тучные клетки выделяют гепарин, гистамин, что вызывает отечность и усиливает миграцию иммунных телец в очаг воспалительного процесса.
Агенты приобретенного иммунитета
Вторая по численности колония иммунных клеток — это лимфоциты. Лимфоцитная популяция составляет до тридцати пяти процентов от общего числа иммуннокомпитентных телец. Лимфоциты относятся к лейкоцитанрным телам, они — основные клетки иммунной системы, им принадлежит ведущая роль в распознании патогенных объектов и формировании иммунологической памяти.
Различают несколько типов клеток, но главными считаются:
- Лимфоциты типа Т;
- Лимфоциты типа В.
Лимфоциты Т
Это клеточные структуры, образованные костным мозгом, которые продолжают свое формирование в вилочковой железе с помощью специальных гормонов, а затем в селезенке и лимфатических узлах. В тимусе и органах лимфатической системы лимфоциты приобретают специфические рецепторы, обучаются и получают функции в зависимости от полученной иммунной памяти.
Лимфоциты начинают действовать после взаимосвязи с фагоцитами, вследствие которой последние передает информацию о проникновении патогена, затем они совместно направляют свои возможности на уничтожение врага. Но, в отличии от фагоцитных клеток, лимфоциты запоминают чужеродный объект после уничтожения. При его повторном внедрении, Т клетки координируют быстрое наступление эффективного иммунного ответа.

Различают виды Т клеток:
- Киллеры — имеют направленное действие на уничтожение патогена, собственных погибших или поврежденных клеток, активирует иммунный ответ;
- Хелперы — предназначены усиливать иммунный адаптационный ответ, усиливают активность В клеток, киллеров, лимфоцитов, моноцитов, естественных киллеров, производят синтез цитокинов;
- Регуляторы — немногочисленная популяция телец, призванная выполнять функции по распознаванию липидных антигенных объектов.
Также лимфоциты Т участвуют в формировании цитотоксического иммунитета.
Лимфоциты В
Лимфоцитные клетки, синтезирующиеся в красном костном мозге и мигрирующие в селезенку и лимфатическую систему для дальнейшего формирования посредством контакта с антигенами или лимфоцитами типа Т непосредственно участвующие в формировании гуморального иммунитета — это лимфоциты типа В. До момента полной формировки, В клетки находятся в виде «наивных» тел, не контактировавших с чужеродным геном или клетками Т. После окончательного формирования они приобретают вид:
- Плазматических телец, функции которых направлены на продуцирование антител, благодаря тому, что у них развивается сеть эндоплазмотического характера, а так же приобретается комплекс Гольджи. В крови повышенный уровень плазматических клеток держится до полного уничтожения и выведения патогена;
- Клеток памяти иммунитета — это небольшой процент лимфоцитных тел типа В, которые взаимодействовали с Т клетками. После чего, «наивные» В клетки изменяются в своем строении и биохимическом составе, вследствие чего сохраняют полученную информацию о возбудителе болезни.
Для клеток лимфоцитарного типа В характерно наличие на их поверхности мембраносвязанных антител в виде иммуноглобулинов М, Д и поверхностных активных веществ, что и образует комплекс, способный распознавать чужеродные частицы.
Так же рассматривается типизация лимфоцитов В по классам:
- Класс В1 — обеспечивает продуцирование антител в виде белковых иммуноглобулиновых соединений М, что отвечает за образование иммунного ответа на недавно внедрившегося в организм чужегенного объекта, который смог пройти первую линию обороны местного иммунитета;
- Класс В2 — способны формировать антитела в виде иммуноглобулинов G, вследствие того, что инфицирование произошло довольно успешно и патоген начал свое распространение по организму.
Вспомогательные иммунные клетки
К иммунокомпитентным клеткам относятся тельца, которые не имеют непосредственного участия в иммунологическом ответе, но играют важную роль в качестве, эффективности и своевременности его наступления. К таким клеткам относятся:
- Тромбоциты — нормализуют состав крови, ток эритроцитов, помогают реализовывать защитную и регенерационную функции внутренних органов;
- Красные кровяные клетки — эритроциты, предоставляют биологически активные вещества лимфоцитам, модулируя иммунный ответ его специфическую и неспецифическую части благодаря переносу антител, участвует в гемостазе;
- Сосудистые эндотелии — способствует синтезу большого количества активных биологических веществ, являющихся неотъемлемой частью иммунных реакций на клеточном и гуморальном уровнях.
Иммунокомпитентные клетки являются основой иммунной системы человека. Благодаря совокупности их действий наступает своевременный клеточный и гуморальный иммунологический ответ, что обеспечивает полноценную здоровую жизнедеятельность организма.
Видео
imunohelp.ru
Иммунная система организма человека — органы, виды и принципы работы
Что такое иммунная система организма человека, что входит в состав органов иммунной системы, какие виды иммунитета существуют, принципы его работы, читайте подробнее в этой статье

Иммунная система организма человека
С того самого момента, как человек рождается и всю свою дальнейшую жизнь он, к сожалению, подвергается постоянным нападениям и атакам всевозможных бактерий, вирусов, различных инфекций и ядов.
Удивительно то, что заболевает человек не так уж и часто, во всяком случае, это происходит намного реже, чем процессы заражения.
В чём же причина этого?
А причина в том, что у человека есть так называемый иммунитет.
В организмах животных и человека существует иммунная система, так называемый иммунитет, который функционирует благодаря работе целого ряда внутренних органов.
Эти органы производят или накапливают лейкоциты, которые, в свою очередь, вырабатывают антитела.
Иммунитет(лат. immunitas — освобождение, избавление от чего-либо) — это совокупность защитных механизмов, которые помогают организму бороться с разными чужеродными факторами, бактериями, вирусами, ядами, посторонними телами и т. д.
Обеспечивает гомеостаз организма на клеточном и молекулярном уровне организации. Реализуется иммунной системой. wiki
Иммунитет – это способность живых организмов распознавать антигены и уничтожать их.
Антигены – это чужеродные тела и вещества, попадающие в организм извне.
Когда они попадают в организм, то иммунная система сразу же реагирует на это и выделяет для борьбы антитела. Антитела подавляют любую активность вирусов, бактерий, токсинов и т.д.
Сам процесс взаимодействия антитела и антигена называют иммунной реакцией (ответом) организма.
Когда возникла иммунная система организма человека?
Это произошло в процессе эволюции для того, чтобы способствовать естественному отбору и выживанию живого организма.
Сама суть иммунитета в плане биологического смысла заключается в том, чтобы обеспечить генетическую целостность организма, сохранить её на протяжении всей его индивидуальной жизни.
Резервы (запасы жизненной силы) человеческого тела огромны, и, соответственно, огромна сама способность нашего организма мощно противостоять вторжениям в организм различной инфекции, паразитам, бактериям и вирусам.
Как только происходит малейшая попытка проникновения внутрь человеческого организма любого паразита или другого чужеродного вещества, наше тело мгновенно мобилизует свои силы и включает защиту!!!
Органы иммунной системы

Их делят на два основных типа:
- центральные органы;
- периферические органы иммунной системы.
Центральные органы – это красный костный мозг и тимус, называемый ещё вилочковая железа.
Периферические органы – это селезенка, все лимфатические узлы на теле и пейеровы бляшки.
- Красный костный мозг
Он жидкий по своей структуре и бывает как активным, так и неактивным. Это вещество, которое заполняет всё внутреннее пространство костной губчатой ткани. Самая большая концентрация красного костного мозга содержится в самых концах длинных костей.
У маленьких детей активный красный костный мозг располагается практически во всех костях, у подростков и взрослых, в основном, располагается в грудине, в костях черепа, костях ребер и малого таза.
Основные функции красного костного мозга – это кроветворение и формирование иммунитета, так называемый иммуногенез. Он всегда работает в постоянном режиме и воспроизводит кровяные клетки – лейкоциты, эритроциты и тромбоциты.
- Тимус (вилочковая железа)
Это эндокринная железа, которая расположена в верхней части грудной клетки, за грудиной. Она играет важнейшую роль в формировании иммунитета и стимулирует развитие «тимусных клеток» в ткани.
Эти клетки распознают и атакуют попавшие в организм извне чужеродные вещества, вирусы и бактерии, а также они контролируют выработку антител.
Основные функции тимуса:
- участие в защите организма от вирусных и бактериальных вторжений извне
- синтез биологически активных веществ и гормонов
- осуществление тщательного отбора тимусных клеток ( Т-лимфоцитов).
У новорожденного младенца вилочковая железа – это две доли, которые соединены между собой так называемым перешейком. В этом перешейке находятся корковое и мозговое вещества.
Корковое вещество – это целая сеть клеток эпителия, в которых находятся скопле- ния лимфоцитов.
В мозговом веществе находится небольшое количество лимфоцитов.
Масса тимуса увеличивается с возрастом и к 15 годам достигает примерно 30 г.
Это орган, который находится в брюшной полости. Он напоминает форму яйца, имеет красный оттенок. Его масса примерно 150-200 грамм.
Основные функции селезёнки:
- высвобождение накопленной крови, повышение общего кровоснабжения организма и обогащение тканей тела кислородом;
- разрушение отживших эритроцитов;
- служит как главный источник лимфоцитов;
- является фильтром для всякого рода опасных бактерий, производит антитела и обеспечивает организму детоксикацию.
Селезёнка находится в соприкосновении с диафрагмой, поджелудочной железой, толстой кишкой и левой почкой.
- Лимфатические узлы
Это многочисленные органы иммунной системы. У взрослого человека их около пятисот. Они расположены по пути тока лимфы. Это такие образования круглой или овальной формы, размер которых от 2 до 20 мм. Находятся они в местах слияния лимфатических сосудов – под мышками, в паху, в шее, в области таза.
Лимфатический узел состоит из соединительнотканной капсулы и лимфоидной ткани. Он служит барьером для распространения инфекции и раковых клеток по организму. В лимфатическом узле образуются лимфоциты, которые активно участвуют в уничтожении чужеродных веществ и клеток.
Основные функции лимфатических узлов:
- задержка бактерий и вирусов по пути тока лимфы;
- кроветворная функция.
Интересно знать!!!
Каждый день происходит потеря нашим организмом около 1×1011 клеток крови, которые, старея и разрушаясь, заменяются на равное количество новых клеток!
- Пейеровы бляшки
Это узелковые скопления овальной или круглой формы, которые находятся в лимфоидной ткани. Располагаются они в слизистой оболочке тонкой кишки. Их диаметр – от 0,5 до 3 мм.
Основные функции пейеровых бляшек:
- участие в процессе созревания Т- и В-лимфоцитов;
- формирование иммунного ответа организма.
Основные функции иммунной системы
Конечная цель работы иммунной системы – это полная ликвидация чужеродного вещества, попавшего в организм.
Различают клеточный и гуморальный иммунитет.
- Клеточный иммунитет – это процесс уничтожения чужеродных тел при помощи клеток.
- Гуморальный иммунитет – это процесс удаления из тела чужеродных веществ при помощи антител.
Более того, иммунная система обеспечивает замену отработанных клеток различных органов на новые, контролирует процесс регенерации клеток, которые поражены инфекцией.
Клетки иммунной системы (лейкоциты) уничтожают чужеродные тела и поврежденные клетки организма, после чего они гибнут.
Гной, который образуется в тканях при любых воспалениях – это и есть погибшие лейкоциты.
Лейкоциты – клетки иммунной системы

Это клетки крови белого цвета, а вернее будет сказать, что они бесцветны. Их форма – круглая, напоминающая почку или много долек.
Размер самих лейкоцитов очень маленький, и он бывает разный – от 6 до 20 ммк. Количество лейкоцитов в 1 мл кубическом в крови у взрослого человека составляет примерно от 5000 до 10 000.
Их самая основная функция – это защитить организм от инфекций, поглотить и уничтожить чужеродные опасные бактерии и вирусы, грибки и паразиты, попавшие в организм извне.
Такой процесс распознавания и уничтожения бактерий называют фагоцитозом.
Какие виды лейкоцитов существуют?
1. Фагоциты (макрофаги). Они составляют около 70 % от общего числа всех лейкоцитов в организме
Макрофаги участвуют в процессе фагоцитоза, поглощая и переваривая болезнетворные бактерии.
2. Лимфоциты. Они образуются в тимусе и лимфоидной ткани из клеток костномозгового происхождения.
Функции лимфоцитов тимуса и лимфоцитов лимфатических узлов несколько отличаются, отлично дополняя друг друга.
Существует два основных типа лимфоцитов — Т- и В-лимфоциты.
Т-лимфоциты распознают и уничтожают клетки, которые несут чужеродные антигены, а также они образовывают антитела и мобилизуют все лейкоциты организма на борьбу с антигеном.
Выделяют 3 их основных подвида:
- Т-хелперы – они распознают антиген;
- Т-киллеры – они уничтожают чужеродные клетки;
- Т-супрессоры – они регулируют активность лимфоцитов, тем самым препятствуют чрезмерному развитию иммунных реакций.
б) В-лимфоциты тоже обладают иммунной памятью, они производят антитела и уничтожают опухолевые клетки.
Как работает иммунная система организма человека?
Всё зависит, прежде всего, от того, какой антиген проник в организм – бактерия это или вирус.
Бактерии — это одноклеточные организмы, которые в зависимости от формы делятся на кокки (шаровидные), бациллы (в виде палочек), вибрионы (изогнутые в виде запятой) и спиралевидные.
- В чём сложность борьбы с бактериями для иммунной системы?
Бактерии перемещаются с помощью жгутиков, поэтому им удается быстрее миновать скопления фагоцитов. К тому же, клеточная стенка бактерии очень прочна, и фагоциты не способны ее переварить.
Более того, бактерии выделяют токсины, которые убивают иммунные клетки.
Вирусы — это мельчайшие неклеточные частицы, которые содержат одну молекулу РНК или ДНК.
Существует несколько групп вирусов:
- сферические вирусы;
- палочковидные вирусы;
- кубоидальные;
- винтообразные;
- вирусы-двадцатигранники.
- В чём сложность борьбы с вирусами для иммунной системы?
Вирусы, проникая в клетки тела, очень быстро размножаются. К тому же, фагоциты не способны их уничтожить.
Как работают Т-лимфоциты:
- Происходит распознавание бактерий по типу.
- Определяется наличие бактерии данного типа, которая уже когда-либо проникала в организм.
- «Ответ» Т-лимфоцитов В-лимфоцитам о том, какой реагент нужно подготовить для уничтожения.

Как работают В-лимфоциты:
- Вырабатываются антитела (иммуноглобулины).
- Антитела уничтожают бактерии.
- Окончательное разрушение чужеродной клетки и остановка Т-супрессорами процесса иммунологической реакции.
Как борется иммунная система с вирусом ?
Т-лимфоциты вместе с В-лимфоцитами производят антитела, которые распознают антигены вирусов и уничтожают все зараженные ими клетки организма.
Такие Т-лимфоциты называют цитотоксическими. Они прекращают размножение вируса любого вида.
У Т-лимфоцитов «короткая память», поэтому этот процесс может быть довольно затяжным.
Виды иммунитета организма человека

У человеческого организма довольно много различных систем защиты тела. И это самое многообразие помогает человеку быть практически невосприимчивым к вторжению в организм различных инфекций, бактерий, вирусов и грибков.
На данный момент научной медицине известны два вида иммунитета:
- естественный иммунитет;
- искусственный иммунитет.
Каждый из этих двух видов делится ещё, в свою очередь, на:
- активный иммунитет;
- пассивный иммунитет.
Что такое естественный иммунитет?
Активный естественный иммунитет разделяют на:
- видовой,
- наследственный,
- приобретенный в течение определённой болезни.
Видовой иммунитет – это абсолютная невосприимчивость организма к инфекционным агентам, которая обусловлена определёнными биологическими причинами от рождения человека или животного.
Про этот вид иммунитета можно сказать, что он – наследственный, и передаётся по наследству так же, как и целый ряд других генетических признаков (особенностей).
Наследственный иммунитет (его ещё называют неспецифическим, конституционным, врождённым) передается организму вместе с другим генетическим наследственным материалом.
Ему обычно свойственны атомические, физиологические, клеточные, а также молекулярные особенности, которые закреплены наследственно.
У этого вида иммунитета, как правило, нет особо строгой специфичности к антигенам, и он не имеет память о самом первом контакте с определённым чужеродным агентом.
Например, исследованиями уже установлено, что многие люди от рождения абсолютно не восприимчивы ко многим видам инфекции, ко многим заболеваниям, даже к очень сильным их возбудителям. Уже доказано, что некоторые люди невосприимчивы даже таким страшным заболеваниям, как туберкулез и СПИД!
Что такое приобретенный или пассивный иммунитет?
Приобретенный иммунитет – это такой вид иммунитета, который формируется на протяжении всей жизни человека или животного. Он не присутствует от момента рождения и может передаваться по наследству.
Приобретенный иммунитет формируется в организме в ходе болезни, во время её протекания. Когда тело болеет, то организм способен сам выработать антитела к какому-то определённому виду инфекции извне, а также имеет способность сохранить в своих клетках определённого рода память об этом антигене на случай повторного заболевания такой же болезнью или вторжению чужеродного агента в организм.
Организм после этого становится невосприимчивым к этому виду вредоносного агента.
Сама невосприимчивость организма может сохраняться на всю жизнь, может быть кратковременной, а может – довольно длительной.
Например, после того, как человек перенёс такое заболевание, как корь, иммунитет к этому вирусу остаётся на всю оставшуюся жизнь.
Если человек переболел брюшным тифом, то невосприимчивость будет довольно длительной, но не пожизненной.
А вот после перенесённого гриппа какого-либо вида, иммунитет к этому вирусу будет недолгим, кратковременным.
Пассивный естественный иммунитет возникает в организме тогда, когда антитела передаются будущему ребёнку, находящемуся в утробе у беременной женщины, через плаценту. Также, когда женщина кормит грудью младенца. Через материнское молоко он получает иммунитет к определённым вирусам и микробам.
Это помогает малышу в дальнейшем быть невосприимчивым ко многим возбудителям инфекций и иметь крепкий иммунитет к ним в течение примерно первого полугода его жизни.
Затем пассивный естественный иммунитет постепенно ослабевает и сходит на нет.
Иммунная система организма человека – видео
Что такое искусственный иммунитет?
Активный искусственный иммунитет развивается после того, как в организм была введена определённого рода вакцина.
После такой манипуляции организм начинает активно вырабатывать иммунитет – собственную невосприимчивость к определённому виду инфекции и производит свои собственные антитела к ней.
Пассивный искусственный иммунитет начинает формироваться после того, как в организм ввели определённую лечебную сыворотку, которая уже содержит антитела, которые были ранее выработаны в организме донора.
В таком случае иммунная защита реагирует довольно пассивно, и не принимает участия в развитии необходимого иммунного ответа организма.
Такой способ иммунизации используется только тогда, когда сама болезнь уже началась. Пассивный искусственный иммунитет приобретается в довольно короткие сроки, оченбь быстро. Как правило, для этого необходимо всего несколько часов.
Но и сохраняется он, к сожалению, тоже совсем недолго, зачастую до одного месяца максимум.
Другие известные виды иммунитета?
Различают ещё три вида иммунитета в зависимости от того, к чему они развиваются:
- Антиинфекционный иммунитет;
- Антитоксический иммунитет;
- Противоопухолевый иммунитет.
Антиинфекционный иммунитет – это иммунитет к микробам и вирусам. Он противостоит повторному заражению данным видом инфекции, к примеру, заражению ветряной оспой.
Антитоксический иммунитет вырабатывает невосприимчивость к токсину болезни после введения в организм сыворотки. Например, после введения противостолбнячной сыворотки в организм, вырабатывается невосприимчивость к токсину столбняка. А не к самой столбнячной палочке. То есть, на саму столбнячную палочку эта сыворотка никак не влияет, как и вырабатываемые с её помощью антитела. Эти антитела всего лишь имеют способность связать столбнячный токсин. Поэтому столбняк, как и многие другие заболевания, могут случаться не единожды в течение жизни.
Противоопухолевый иммунитет – это своего рода «надзор» за работой и состоянием клеток всего организма, а точнее – выявление и разрушение обнаруженных видоизменённых клеток (злокачественных), потенциально опасных для здоровья в плане развития из них опухолей.
Что такое локальный иммунитет?
Когда в организм поступают антигены через дыхательные пути, через пищеварительный тракт, через слизистые оболочки, кожу, то организм начинает вырабатывать локальный иммунитет к ним.
Это всевозможные защитные способы организма, призванные сохранить ему здоровье при взаимодействии с внешней средой.
Локальный иммунитет способен самостоятельно, без включения общего иммунитета, защитить внутренние среды от вторжений потенциально опасных чужеродных агентов, мгновенно нейтрализуя их в самом начале их «посягательства» на организм.
Но, несмотря на то, что запасы сил у каждого организма огромны, ресурсы нашего тела могут постепенно иссякнуть, если не «подзаряжать батарейки», другими словами – необходимо научится правильно поддерживать свой иммунитет и укреплять его для того, чтобы он мог функционировать в мощном режиме, охраняя наше здоровье!!!
Существует масса методик и способов, как это сделать.
И здесь самое главное, что надо понять для себя – это то, что самолечение может быть опасным, особенно, если у вас уже имеются хронические заболевания, особенно в стадии обострения!
Поэтому, приступая к укреплению и усилению своего иммунитета, проконсультируйтесь со своим лечащим врачом о тех способах, которые вы хотите применить для этой цели!
И далее, в процессе любых манипуляций, обязательно отслеживайте своё состояние. При малейших проявлениях дискомфорта – реагируйте немедленно!
Особенно это касается пожилых людей, детей, беременных и тех, кто болен хроническими заболеваниями.
Надеемся, что эта статья смогла объяснить основное понятие о том, что такое иммунная система организма человека .
Будьте здоровы!
alternative-medicina.ru
I. Понятие иммунная система
Введение
Под иммунитетом понимают совокупность биологических явлений, направленных на сохранение внутренней среды и защиту организма от инфекционных и других генетически чужеродных для него агентов. Существуют следующие виды инфекционного иммунитета:
антибактериальный
антитоксический
противовирусный
противогрибковый
антипротозойный
Инфекционный иммунитет может быть стерильным (возбудителя в организме нет) и нестерильным (возбудитель в организме). Врожденный иммунитет имеется с рождения, он может быть видовым и индивидуальным. Видовой иммунитет – невосприимчивость одного вида животного или человека к микроорганизмам, вызывающим заболевание у других видов. Он генетически детерминирован у человека как биологического вида. Видовой иммунитет всегда активен. Индивидуальный иммунитет пассивный (плацентарный иммунитет). Неспецифические факторы защиты следующие: кожа и слизистые оболочки, лимфатические узлы, лизоцим и другие ферменты полости рта и ЖКТ, нормальная микрофлора, воспаление, фагоцитирующие клетки, естественные киллеры, система комплемента, интерфероны. Фагоцитоз.
Иммунная система представляет собой совокупность всех лимфоидных органов и скоплений лимфоидных клеток организма. Лимфоидные органы подразделяются на центральные – тимус, костный мозг, сумка Фабрициуса ( у птиц) и ее аналог у животных — пейеровы бляшки; периферические – селезенка, лимфатические узлы, солитарные фолликулы, кровь и другие. Главный компонент ее – лимфоциты. Выделяют два основных класса лимфоцитов: В-лимфоциты и Т-лимфоциты. Т-клетки участвуют в клеточном иммунитете, регуляции активности В-клеток, гиперчувствительности замедленного типа. Различают следующие субпопуляции Т-лимфоцитов: Т- хелперы (запрограммированы индуцировать размножение и дифференцировку клеток других типов), супрессорные Т-клетки, Т-киллеры (секрктируют цитотоксические димфокины). Основная функция В- лимфоцитов заключается в том, что в ответ на антиген они способны размножаться и дифференцироваться в плазматические клетки, продуцирующие антитела. В – лимфоциты разделяются на две субпопуляции: 15 В1 и В2. В – клетки это долгоживущие В – лимфоциты, произошедшие из зрелых В – клеток в результате стимуляции антигеном при участии Т-лимфоцитов.
Иммунный ответ – это цепь последовательных сложных кооперативных процессов, идущих в иммунной системе в ответ на действие антигена в организме. Различают первичный и вторичный иммунный ответ, каждый из которых состоит из двух фаз: индуктивной и продуктивной. Далее иммунный ответ возможен в виде одного из трех вариантов: клеточный, гуморальный и иммунологическая толерантность. Антигены по происхождению: естественные, искусственные и синтетические; по химической природе: белки, углеводы (декстран), нуклеиновые кислоты, конъюгированные антигены, полипептиды, липиды; по генетическому отношению: аутоантиген, изоантигены, аллоантиген, ксеноантигены. Антитела – это белки, синтезирующиеся под влиянием антигена.
II. Клетки иммунной системы
Иммунокомпетентные клетки — это клетки, входящие в состав иммунной системы. Все эти клетки происходят из единой родоначальной стволовой клетки красного костного мозга. Все клетки делятся на 2 типа: гранулоциты (зернистые) и агранулоциты (незернистые).
К гранулоцитам относят:
нейтрофилы
эозинофилы
базофилы
К агранулоцитам:
Нейтрофильные
гранулоциты или нейтрофилы, сегментоядерные
нейтрофилы, нейтрофильные
лейкоциты —
подвид гранулоцитарных
лейкоцитов,
названный нейтрофилами за то, что при
окраске
по Романовскому
они интенсивно окрашиваются как кислым
красителем эозином,
так и основными красителями, в отличие
от эозинофилов,
окрашиваемых только эозином, и от
базофилов,
окрашиваемых только основными
красителями.
Зрелые нейтрофилы имеют сегментированное ядро, то есть относятся к полиморфноядерным лейкоцитам, или полиморфонуклеарам. Они являются классическими фагоцитами: имеют адгезивность, подвижность, способность к хемостаксису, а так же способность захватывать частицы (например, бактерии).
Зрелые сегментоядерные нейтрофилы в норме являются основным видом лейкоцитов, циркулирующих в крови человека, составляя от 47% до 72% общего количества лейкоцитов крови. Ещё 1—5% в норме составляют юные, функционально незрелые нейтрофилы, имеющие палочкообразное сплошное ядро и не имеющие характерной для зрелых нейтрофилов сегментации ядра — так называемые палочкоядерные нейтрофилы.
Нейтрофилы способны к активному амёбоидному движению, к экстравазации (эмиграции за пределы кровеносных сосудов), и к хемотаксису (преимущественному движению в направлении мест воспаления или повреждения тканей).
Нейтрофилы способны к фагоцитозу, причём являются микрофагами, то есть способны поглощать лишь относительно небольшие чужеродные частицы или клетки. После фагоцитирования чужеродных частиц нейтрофилы обычно погибают, высвобождая большое количество биологически активных веществ, повреждающих бактерии и грибы, усиливающих воспаление и хемотаксис иммунных клеток в очаг. Нейтрофилы содержат большое количество миелопероксидазы, фермента, который способен окислять анион хлора до гипохлорита — сильного антибактериального агента. Миелопероксидаза как гем-содержащий белок имеет зеленоватый цвет, что определяет зеленоватый оттенок самих нейтрофилов, цвет гноя и некоторых других выделений, богатых нейтрофилами. Погибшие нейтрофилы вместе с клеточным детритом из разрушенных воспалением тканей и гноеродными микроорганизмами, послужившими причиной воспаления, формируют массу, известную как гной.
Повышение доли нейтрофилов в крови называется относительным нейтрофилёзом, или относительным нейтрофильным лейкоцитозом. Повышение абсолютного числа нейтрофилов в крови называется абсолютным нейтрофилёзом. Снижение доли нейтрофилов в крови называется относительной нейтропенией. Снижение абсолютного числа нейтрофилов в крови обозначается как абсолютная нейтропения.
Нейтрофилы играют очень важную роль в защите организма от бактериальных и грибковых инфекций, и сравнительно меньшую — в защите от вирусных инфекций. В противоопухолевой или антигельминтной защите нейтрофилы практически не играют роли.
Нейтрофильный ответ (инфильтрация очага воспаления нейтрофилами, повышение числа нейтрофилов в крови, сдвиг лейкоцитарной формулы влево с увеличением доли «юных» форм, указывающий на усиление продукции нейтрофилов костным мозгом) — самый первый ответ на бактериальные и многие другие инфекции. Нейтрофильный ответ при острых воспалениях и инфекциях всегда предшествует более специфическому лимфоцитарному. При хронических воспалениях и инфекциях роль нейтрофилов незначительна и преобладает лимфоцитарный ответ (инфильтрация очага воспаления лимфоцитами, абсолютный или относительный лимфоцитоз в крови).
Эозинофильные
гранулоциты или эозинофилы, сегментоядерные
эозинофилы, эозинофильные
лейкоциты — подвид гранулоцитарных
лейкоцитов
крови.
Эозинофилы названы так потому, что при окраске по Романовскому интенсивно окрашиваются кислым красителем эозином и не окрашиваются основными красителями, в отличие от базофилов (окрашиваются только основными красителями) и от нейтрофилов (поглощают оба типа красителей). Так же отличительным признаком эозинофила является двудольчатое ядро (у нейтрофила оно имеет 4-5 долей, а у базофила не сегментировано).
Эозинофилы способны к активному амебоидному движению, к экстравазации (проникновению за пределы стенок кровеносных сосудов) и к хемотаксису (преимущественному движению в направлении очага воспаления или повреждения ткани).
Эозинофилы, как и нейтрофилы, способны к фагоцитозу, причём являются микрофагами, то есть способны, в отличие от макрофагов, поглощать лишь относительно мелкие чужеродные частицы или клетки. Однако, эозинофил не является «классическим» фагоцитом, его главная роль не в фагоцитозе. Главнейшее их свойство — экспрессия Fc-рецепторов, специфичных для Ig E. Физиологически это проявляется в мощных цитотоксических, а не фагоцитарных, свойствах эозинофилов, и их активном участии в противопаразитарном иммунитете. Однако, повышенная продукция антител класса E может привести к аллергической реакции немедленного типа (анафилактический шок), что является главным механизмом всех аллергий такого типа.
Также эозинофилы способны поглощать и связывать гистамин и ряд других медиаторов аллергии и воспаления. Они также обладают способностью при необходимости высвобождать эти вещества, подобно базофилам. То есть эозинофилы способны играть как про-аллергическую, так и защитную анти-аллергическую роль. Процентное содержание эозинофилов в крови увеличивается при аллергических состояниях.
Эозинофилы менее многочисленны, чем нейтрофилы. Большая часть эозинофилов недолго остаётся в крови и, попадая в ткани, длительное время находится там.
Нормальным уровнем для человека считается 120—350 эозинофилов на микролитр.
Базофильные
гранулоциты или базофилы, сегментоядерные
базофилы, базофильные
лейкоциты —
подвид гранулоцитарных
лейкоцитов.
Содержат базофильное S-образное ядро,
зачастую не видимое из-за перекрытия
цитоплазмы гранулами гистамина и прочих
аллергомедиаторов. Базофилы названы
так за то, что при окраске
по Романовскому
интенсивно поглощают основной
краситель и не окрашиваются кислым
эозином,
в отличие и от эозинофилов,
окрашиваемых только эозином, и от
нейтрофилов,
поглощающих оба красителя.
Базофилы — очень крупные гранулоциты: они крупнее и нейтрофилов, и эозинофилов. Гранулы базофилов содержат большое количество гистамина, серотонина, лейкотриенов, простагландинов и других медиаторов аллергии и воспаления.
Базофилы принимают активное участие в развитии аллергических реакций немедленного типа (реакции анафилактического шока). Существует заблуждение, что базофилы являются предшественниками лаброцитов. Тучные клетки очень похожи на базофилов. Обе клетки имеют грануляцию, содержат гистамин и гепарин. Обе клетки также выделяют гистамин при связывании с иммуноглобулином Е. Это сходство заставило многих предположить, что тучные клетки и есть базофилы в тканях. Кроме того, они имеют общий предшественник в костном мозге. Тем не менее базофилы покидают костный мозг уже зрелым, в то время как тучные клетки циркулируют в незрелом виде, только со временем попадают в ткани. Благодаря базофилам яды насекомых или животных сразу блокируются в тканях и не распространяются по всему телу. Также базофилы регулируют свертываемость крови при помощи гепарина. Однако исходное утверждение всё же верно: базофилы являются прямыми родственниками и аналогами тканевых лаброцитов, или тучных клеток. Подобно тканевым лаброцитам, базофилы несут на поверхности иммуноглобулин E и способны к дегрануляции (высвобождению содержимого гранул во внешнюю среду) или аутолизу (растворению, лизису клетки) при контакте с антигеном-аллергеном. При дегрануляции или лизисе базофила высвобождается большое количество гистамина, серотонина, лейкотриенов, простагландинов и других биологически активных веществ. Это и обусловливает наблюдаемые проявления аллергии и воспаления при воздействии аллергенов.
Базофилы способны к экстравазации (эмиграции за пределы кровеносных сосудов), причём могут жить вне кровеносного русла, становясь резидентными тканевыми лаброцитами (тучными клетками).
Базофилы
обладают способностью к хемотаксису
и фагоцитозу.
Кроме того, по всей видимости, фагоцитоз
не является для базофилов ни основной,
ни естественной (осуществляемой в
естественных физиологических условиях)
активностью. Единственная их функция
— мгновенная дегрануляция, ведущая к
усилению кровотока, увеличению
проницаемости сосудов. росту притока
жидкости и прочих гранулоцитов. Другими
словами, главная функция базофилов
заключается в мобилизации остальных
гранулоцитов в очаг воспаления.
Моноцит — крупный зрелый одноядерный лейкоцит группы агранулоцитов диаметром 18—20 мкм с эксцентрично расположенным полиморфным ядром, имеющим рыхлую хроматиновую сеть, и азурофильной зернистостью в цитоплазме. Как и лимфоциты, моноциты имеют несегментированное ядро. Моноцит — наиболее активный фагоцит периферической крови. Клетка овальной формы с крупным бобовидным, богатым хроматином ядром (что позволяет отличать их от лимфоцитов, имеющих округлое тёмное ядро) и большим количеством цитоплазмы, в которой имеется множество лизосом.
Помимо крови, эти клетки всегда присутствуют в больших количествах в лимфатических узлах, стенках альвеол и синусах печени, селезенки и костного мозга.
Моноциты находятся в крови 2-3 дня, затем они выходят в окружающие ткани, где, достигнув зрелости, превращаются в тканевые макрофаги — гистиоциты. Моноциты также являются предшественниками клеток Лангерганса, клеток микроглии и других клеток, способных к переработке и представлению антигена.
Моноциты обладают выраженной фагоцитарной функцией. Это самые крупные клетки периферической крови, они являются макрофагами, то есть могут поглощать относительно крупные частицы и клетки или большое количество мелких частиц и как правило не погибают после фагоцитирования (возможна гибель моноцитов при наличии у фагоцитированного материала каких-либо цитотоксических для моноцита свойств). Этим они отличаются от микрофагов — нейтрофилов и эозинофилов, способных поглощать лишь относительно небольшие частицы и как правило погибающих после фагоцитирования.
Моноциты способны фагоцитировать микробов в кислой среде, когда нейтрофилы неактивны. Фагоцитируя микробов, погибших лейкоцитов, поврежденные клетки тканей, моноциты очищают место воспаления и подготавливают его для регенерации. Эти клетки образуют отграничивающий вал вокруг неразрушаемых инородных тел.
Активированные моноциты и тканевые макрофаги:
осуществляют противоопухолевый, противовирусный, противомикробный и противопаразитарный иммунитет, производяцитотоксины,интерлейкин(ИЛ-1),фактор некроза опухоли(ФНО),интерферон
участвуют в регуляции гемопоэза(кроветворения)
принимают участие в формировании специфического иммунного ответа организма.
Моноциты, выходя из кровяного русла, становятся макрофагами, которые наряду с нейтрофилами являются главными «профессиональными фагоцитами». Макрофаги, однако, значительно больше по размерам и дольше живут, чем нейтрофилы. Клетки-предшественницы макрофагов — моноциты, выйдя из костного мозга, в течение нескольких суток циркулируют в крови, а затем мигрируют в ткани и растут там. В это время в них увеличивается содержание лизосом и митохондрий. Вблизи воспалительного очага они могут размножаться делением.
Моноциты способны, эмигрировав в ткани, превращаться в резидентные тканевые макрофаги. Моноциты также способны, подобно другим макрофагам, выполнять процессинг антигенов и представлять антигены Т-лимфоцитам для распознавания и обучения, то есть являются антигенпрезентирующими клетками иммунной системы.
Макрофаги — это большие клетки, активно разрушающие бактерии. Макрофаги в больших количествах накапливаются в очагах воспаления. По сравнению с нейтрофилами моноциты более активны в отношении вирусов, чем бактерий, и не разрушаются во время реакции с чужеродным антигеном, поэтому в очагах воспаления вызванного вирусами гной не формируется. Также моноциты накапливаются в очагах хронического воспаления.
Моноциты секретируют растворимые цитокины, оказывающие воздействие на функционирование других звеньев иммунной системы. Цитокины, секретируемые моноцитами, называют монокинами.
Моноциты синтезируют отдельные компоненты системы комплемента. Они распознают антиген и переводят его в иммуногенную форму (презентация антигена).
Моноциты
продуцируют как факторы,
усиливающие свертывание крови
(тромбоксаны,
тромбопластины),
так и факторы, стимулирующие фибринолиз
(активаторы
плазминогена).
В отличие от В-
и Т-лимфоцитов,
макрофаги и моноциты не способны к
специфическому распознаванию антигена.
T-лимфоциты, или Т-клетки — лимфоциты, развивающиеся у млекопитающих в тимусе из предшественников — претимоцитов, поступающих в него из красного костного мозга. В тимусе T-лимфоциты дифференцируются, приобретая Т-клеточные рецепторы (TCR) и различные ко-рецепторы (поверхностные маркеры). Играют важную роль в приобретённом иммунном ответе. Обеспечивают распознавание и уничтожение клеток, несущих чужеродные антигены, усиливают действие моноцитов, NK-клеток, а также принимают участие в переключении изотипов иммуноглобулинов (в начале иммунного ответа B-клетки синтезируют IgM, позже переключаются на продукцию IgG, IgE, IgA).
Типы Т-лимфоцитов:
Т-клеточные рецепторыявляются основными поверхностными белковыми комплексами Т-лимфоцитов, ответственными за распознавание процессированных антигенов, связанных с молекуламиглавного комплекса гистосовместимостина поверхностиантигенпрезентирующих клеток. Т-клеточный рецептор связан с другим полипептидным мембранным комплексом,CD3. В функции CD3 комплекса входит передача сигналов в клетку, а так же стабилизация Т-клеточного рецептора на поверхности мембраны. Т-клеточный рецептор может ассоциироваться с другими поверхностными белками, TCRкорецепторами. В зависимости откорецептораи выполняемых функций различают два основных типа Т клеток.
Т-хелперы- Т-лимфоциты, главной функцией которых является усиление адаптивного иммунного ответа. Активируют Т-киллеры,B-лимфоциты,моноциты, NK-клетки при прямом контакте, а также гуморально, выделяяцитокины. Основным признаком Т-хелперов служит наличие на поверхности клетки молекулыкорецептораCD4. Т-хелперы распознают антигены при взаимодействии их Т-клеточного рецептора с антигеном, связанным с молекулами главного комплекса гистосовместимости II класса.
Т-киллеры, цитотоксические T-лимфоциты, CTL — Т-лимфоциты, главной функцией которых является уничтожение повреждённых клеток собственного организма. Мишени Т-киллеров — это клетки, поражённые внутриклеточными паразитами (к которым относятся вирусы и некоторые виды бактерий), опухолевые клетки. Т-киллеры являются главным компонентом антивирусного иммунитета. Основным признаком Т-киллеров служит наличие на поверхности клетки молекулыкорецептораCD8. Т-киллеры распознают антигены при взаимодействии их Т-клеточного рецептора с антигеном, связанным с молекулами главного комплекса гистосовместимости I класса.
Т-хелперы и Т-киллеры образуют группу эффекторных Т-лимфоцитов, непосредственно ответственных за иммунный ответ. В то же время существует другая группа клеток, регуляторные Т-лимфоциты, функция которых заключается в регулировании активности эффекторных Т-лимфоцитов. Модулируя силу и продолжительность иммунного ответа через регуляцию активности Т-эффекторных клеток, регуляторные Т-клетки поддерживают толерантность к собственным антигенам организма и предотвращают развитие аутоиммунных заболеваний. Существуют несколько механизмов супрессии: прямой, при непосредственном контакте между клетками, и дистантный, осуществляющийся на расстоянии — например, через растворимые цитокины.
γδ
Т-лимфоциты представляют собой небольшую
популяцию клеток с видоизмененным
Т-клеточным рецептором. В отличие от
большинства других Т-клеток, рецептор
которых образован двумя α и β субъеденицами,
Т-клеточный рецептор γδ лимфоцитов
образован γ и δ субъеденицами. Данные
субъеденицы не взаимодействуют с
пептиднымиантигенами презентированными MHC
комплексами. Предполагается, что γδ
Т-лимфоциты участвуют в узнаваниилипидныхантигенов.
B-лимфоциты (B-клетки, от bursa fabricii птиц, где впервые были обнаружены) — функциональный тип лимфоцитов, играющих важную роль в обеспечении гуморального иммунитета. При контакте с антигеном или стимуляции со стороны T-клеток некоторые B-лимфоциты трансформируются в плазматические клетки, способные к продукции антител. Другие активированные B-лимфоциты превращаются в B-клетки памяти. Помимо продукции антител, В-клетки выполняют множество других функций: выступают в качестве антигенпрезентирующих клеток, продуцируют цитокины и экзосомы.
У эмбрионов человека и других млекопитающих B-лимфоциты образуются в печени и костном мозге из стволовых клеток, а у взрослых млекопитающих — только в костном мозге. Дифференцировка В-лимфоцитов проходит в несколько этапов, каждый из которых характеризуется присутствием определённых белковых маркеров и степенью генетической перестройки генов иммуноглобулинов.
Различают следующие типы зрелых В-лимфоцитов:
Собственно В-клетки (ещё называемые «наивными» В-лимфоцитами) — неактивированные В-лимфоциты, не контактировавшие с антигеном. Не содержат тельца Голла, вцитоплазмерассеянымонорибосомы. Полиспецифичны и имеют слабое сродство к многим антигенам.
В-клетки памяти — активированые В-лимфоциты, вновь перешедшие в стадию малых лимфоцитов в результате кооперации с Т-клетками. Являются долгоживущим клоном В-клеток, обеспечивают быстрый иммунный ответи выработку большого количества иммуноглобулинов при повторном введении того же антигена. Названы клетками памяти, так как позволяют иммунной системе «помнить» антиген на протяжении многих лет после прекращения его действия. В-клетки памяти обеспечивают долговременный иммунитет.
Плазматические клетки — являются последним этапом дифференцировки активированных антигеном В-клеток. В отличие от остальных В-клеток несут мало мембранных антител и способны секретировать растворимые антитела. Являются большими клетками с эксцентрично расположенным ядром и развитым синтетическим аппаратом — шероховатый эндоплазматический ретикулумзанимает почти всю цитоплазму, также развит иаппарат Гольджи. Являются короткоживущими клетками (2-3 дня) и быстро элиминируются при отсутствии антигена, вызвавшего иммунный ответ.
Характерной
особенностью В-клеток является наличие
поверхностных мембраносвязанных
антител, относящихся к классам IgM и IgD.
В комплексе с другими поверхностными
молекулами иммуноглобулины формируют
антигенраспознающий рецептивный
комплекс, ответственный за узнавание
антигена. Также на поверхности
В-лимфоцитов расположены антигены МНС
класса II,
важные для взаимодействия с Т-клетками,
также на некоторых клонах В-лимфоцитов
присутствует маркер CD5,
общий с Т-клетками. Рецепторы компонентов
комплемента
C3b (Cr1, CD35) и C3d (Cr2, CD21) играют определённую
роль в активации В-клеток. Следует
отметить, что маркеры CD19,
CD20 и CD22 используются для идентификации
В-лимфоцитов. Также на поверхности
В-лимфоцитов обнаружены Fc
рецепторы.
Натуральные киллеры — большие гранулярные лимфоциты, обладающие цитотоксичностью против опухолевых клеток и клеток, зараженных вирусами. В настоящее время NK-клетки рассматривают как отдельный класс лимфоцитов. NK выполняют цитотоксические и цитокин-продуцирующие функции. NK являются одним из важнейших компонентов клеточного врождённого иммунитета. NK формируются в результате дифференцировки лимфобластов (общих предшественников всех лимфоцитов). Они не имеют Т-клеточных рецепторов, CD3 или поверхностных иммуноглобулинов, но обычно несут на своей поверхности маркеры CD16 и CD56 у людей или NK1.1/NK1.2 у некоторых линий мышей. Около 80 % NK несут CD8.
Эти клетки были названы естественными киллерами, поскольку, по ранним представлениям, они не требовали активации для уничтожения клеток, не несущих маркеров главного комплекса гистосовместимости I типа.
Основная функция NK — уничтожение клеток организма, не несущих на своей поверхности MHC1 и таким образом недоступных для действия основного компонента противовирусного иммунитета — Т-киллеров. Уменьшение количества MHC1 на поверхности клетки может быть следствием трансформации клетки в раковую или действием вирусов, таких как папилломавирус и ВИЧ.
Макрофаги, нейтрофилы, эозинофилы, базофилы и натуральные киллеры обеспечивают прохождение врождённого иммунного ответа, который является неспецифичным.
studfiles.net
Клетки иммунной системы
В реакциях иммунитета главная задача защиты – отличить «своего» от «чужака» и избавить организм от этого «чужака».
Иммунная система представлена различными клетками, каждый вид которых выполняет специфическую задачу, причем их деятельность тесно взаимосвязана. Система обеспечивает два разных типа иммунитета: врожденный и приобретенный.
Врожденный иммунитет представляет собой сопротивляемость бактериям, которая присуща человеку от рождения и передается по наследству.
Приобретенный иммунитет развивается в течение жизни человека по мере столкновения его с теми или иными патогенными микробами и вирусами.
Это кажется невероятным, но иммунная система помнит каждую встречу с бактериями или вирусами и способна в любой момент выработать и пустить в действие вещества, необходимые для уничтожения конкретного врага, если он вновь вторгнется в организм.
В организме человека имеются клетки – носители иммунитета, клетки, наделенные защитными способностями, а также ряд химических веществ – факторы гуморального иммунитета, циркулирующие в крови и тканях. С их помощью наш организм отторгает бактерии, вирусы, болезнетворные грибки. Иммунная система нашего организма противостоит онкологическим заболеваниям.
Познакомимся с элементами иммунной защиты организма человека.
Гранулоциты
Они представляют собой белые кровяные клетки, являющиеся частью большой семьи фагоцитов, клеток-пожирателей микроорганизмов. Это наименее специализированные клетки иммунной системы, которые свободно «путешествуют» по кровяному руслу, приплывая в клетки и ткани при первых признаках попадания туда инфекции. Именно гранулоциты поддерживают здоровое состояние каждого отдельно взятого органа или участка тела, направляясь в места порезов, воспалений и проникновения бактерий. Они «пожирают» все, что покажется им подозрительным. Поглощенные гранулоцитами вещества разрушаются с помощью химических агентов, которые вырабатываются в самом гранулоците, в его лизосомах, продуцирующие такие мощные окислители, как перекись водорода, окись азота и гипохлорид. Гранулоциты воистину переваривают чужеродные элементы. Они как бы ставят барьер вокруг места повреждения и проникновения инфекции, не давая возможности последней проникнуть в глубь организма. В процессе этой борьбы в окружающих тканях образуются свободные радикалы, вызывающие воспаление.
Гранулоциты живут непродолжительное время: от нескольких часов до нескольких дней, а затем погибают. Безусловно, именно гранулоциты останавливают болезнетворные бактерии с минимальными потерями для нашего организма.
Макрофаги
Это также белые кровяные клетки, проходящие по кровяному руслу, но при необходимости способные проникать в ткани. Некоторые органы (почки, печень, кожа и легкие) имеют свои «постоянные» макрофаги. Такие фиксированные макрофаги специализируются по отношению к тем бактериям, которые обычно проникают в организм в местах их постоянного пребывания.
Макрофагов в крови намного меньше, чем гранулоцитов – около 100000 по сравнению с 10000000 гранулоцитов на 1 мл крови.
Макрофаги располагают рецепторами – антеннами, благодаря которым получают информацию о микробной клетке и включается в программу нейтрализации чужеродного микроорганизма.
Активные макрофаги начинают вырабатывать целый спектр химических средств борьбы с бактериями, вирусами и раковыми клетками. Эти вещества буквально испепеляют вражескую клетку.
Микроорганизмы под влиянием окислителей-макрофагов распадаются и погибают.
Пока неизвестно, какой механизм лежит в основе распознавания вирусов или раковых клеток. Нередко раковая опухоль своевременно не распознается, остается как бы не замеченной иммунной системой. Иногда и вирусы не замечаются макрофагами. Задача современных исследований заключается в своевременном распознавании вирусных клеток, раковых клеток, создании новых лекарственных средств, убивающих раковые клетки и опасные вирусы до того, как они смогут причинить организму большой вред.
Сразу после распознавания вируса или раковой клетки макрофаг выделяет в кровь цитокины. Эти вещества вызывают в организме самые разные реакции, в том числе лихорадку, сон.
Макрофаги поставляют информацию Т-лимфоцитам, которые стимулируют мощный иммунный ответ. Т-лимфоциты включают в себя два типа иммунных клеток, каждый из которых способен ввести в действие различные компоненты иммунной системы.
Последовательно рассмотрим их.
Комплемент
Это не клетки, а группа белков, содержащихся в крови, представляющих самый мощный из гуморальных факторов иммунной системы. Поскольку белки состоят из аминокислот, то и комплемент состоит также из аминокислот. Они инициируют защитные реакции при встрече с опасностью.
Как только комплемент обнаруживает чужеродный микроорганизм, он обволакивает его и пробивает бреши в его клеточной мембране, вызывая этим гибель микроорганизма. При этом комплемент выделяет вещества, которые воспринимаются как сигнал тревоги по всему организму. Этим явлением обусловлено покраснение вокруг места проникновения инфекции.
Лимфоциты
При невозможности макрофагов самостоятельно справиться с возбудителем в очаг проникновения посылаются по сигналу Т-лимфоциты, Т-хелперы. Т-хелперы обладают способностью производить одни и мобилизовать другие мощные элементы иммунной системы.
Однако перед тем, как Т-хелпер начинает действовать, он должен получить информацию о присутствии конкретного антигена – бактерии, вируса, чужеродного белка или раковой клетки. Получив сигнал тревоги, Т-хелпер приступает к активизации защитных сил организма. Лишь Т-хелперы способны мобилизовать все силы организма на борьбу с инфекцией.
Реакция Т-хелпера на антиген не происходит автоматически. На поверхности хелпера должен быть специальный рецептор, который точно соответствует антигену, как ключ к замку. Каждый Т-хелпер способен опознать характерные черты лишь своего антигена, но этого вполне достаточно для организации иммунного ответа. Считается, что на миллионы посланий макрофагов реагирует лишь небольшая часть Т-хелперов. У остальных нет специфического рецептора для этого антигена. Рецепторы же на каждом Т-хелпере формируются по команде генов, одинаковых для всех лимфоцитов. Каждая клетка строит свой рецептор на основе генетической матрицы из обширного набора, предлагаемого генами. Обучение лимфоцитов происходит в тимусе (вилочковой железе). Именно там Т-хелперы приобретают специфический рецептор, принимая на себя часть ответственности за иммунный ответ. Как только Т-хелпер получает свой рецептор, он выходит в кровь, готовый к встрече со своим врагом. Через некоторое время лимфоцит разделяется, и его потомство будет обладать тем же рецептором. Если в организм попадут бактерии или вирус, члены этого семейства или клана разбредутся по всему организму и узнают своего врага в любой ткани, в каждом органе.
Важно подчеркнуть, что каждый возбудитель той или иной болезни несет не один, а несколько антигенов, поэтому шансы иммунной системы в опознании врага высоки. Достаточно хелперу опознать своего врага, как он развивает бурную активность. По его сигналу миллионы и миллионы иммунных клеток занимают свои позиции и начинают действовать. Человек в это время чувствует себя дискомфортно: слабость, разбитость, боли, потливость… А в это время все ресурсы организма включаются по сигналам иммунной системы в борьбу с недугом. В работу включаются клетки-киллеры, еще один вид белых кровяных клеток, которые способны убивать бактерии, вирусы и раковые клетки. И все это время иммунная система постоянно учится на собственном опыте, запоминая удачные варианты иммунного ответа, потому при следующей встрече с антигеном у нее будет готовый и организованный план действий.
Если Т-лимфоциты оказываются ослабленными или поврежденными (например, как при заболевании СПИДом), возможности иммунной системы будут неполные, и потому в случае попадания в организм инфекции сопротивление будет осуществлено недостаточно или вовсе ослаблено, приводя к необратимым последствиям.
Если только Т-хелпер узнал антиген, он начинает размножаться, чтобы по организму разошлось как можно больше лимфоцитов с таким же рецептором. И тогда по всему организму распространяются клетки, способные опознать чужеродный микроорганизм, проникший в тело человека.
Цитокины и интерлейкины
Лимфоциты передают информацию цитокинам, которые запускают механизмы изменения иммунной деятельности и обмена веществ. Самыми важными в этих процессах являются интерлейкины (от интерлейкина-1 до интерлейкина-17). Они работают как вместе, так и по отдельности, запуская разные процессы.
Интерлейкин-1 и интерферон делают больного человека сонным. Стоит человеку принять горизонтальное положение, как его организм может мобилизовать силы на борьбу с болезнью.
Иные цитокины вызывают лихорадку, чтобы сделать внутреннюю среду организма менее благоприятной для чужеродного микроорганизма.
Еще одна группа веществ регулирует синтез определенных гормонов, помогая таким образом изменить настроение человека. Всем известно, как проявляются подавленность, раздражительность и утомляемость, вызванные простудой. И все это не что иное, как попытка организма изолироваться и как бы сосредоточиться на борьбе с инфекцией, превращаясь в затворника.
Если одновременно воздействуют интерлейкин-1, интерферон и фактор некроза опухолей, в крови увеличивается концентрация иммунных белков, снижается содержание цинка. Известно, что цинк очень важен для оказания иммунного ответа.
Помните! В этих продуктах содержатся значимые количества цинка (в мг/100 г продукта):
| 148,7 | свежие устрицы |
| 6,8 | имбирный корень |
| 5,6 | бифштекс |
| 5,3 | баранья отбивная |
| 4,5 | орехи |
| 4,2 | сухой лущеный горох |
| 3,9 | печень говяжья |
| 3,5 | яичный желток |
| 3,2 | зерна пшеницы |
| 3,2 | зерна ржи |
| 3,2 | овес |
| 3,2 | арахис |
| 3,1 | фасоль |
| 3,0 | сардины |
| 2,5 | гречиха |
| 2,0 | морские водоросли |
| 1,7 | морская рыба (тунец, пикша) |
| 1,6 | свежий зеленый горошек |
| 1,5 | креветки |
| 1,2 | репа |
| 0,6 | морковь |
| 0,5 | хлеб пшеничный |
| 0,3 | цветная капуста |
| 0,1 | огурцы. |
Цинк содержится также в черном перце, паприке, горчице, чабреце, корице, поэтому рекомендуется использовать эти приправы в систематическом питании для активизации иммунитета.
Интерлейкин-2 также стимулирует размножение Т-хелперов, а также при необходимости запускает производство фактора некроза опухолей. Интерлейкин-2 способствует образованию гамма-интерферона – вещества, которое тормозит размножение вирусов.
Интерлейкины-2, -4 и -6 и интерферон активизируют цитотоксические клетки, которые убивают клетки, зараженные вирусом, или раковые клетки. Непосредственную угрозу раковым клеткам несет фактор некроза опухолей.
Однако не всегда понятна роль интерлейкинов и интерферона в ускорении распада мышечных клеток.
Следует отметить еще одну важную особенность: интерферон заставляет клетки-киллеры набрасываться на антиген.
β-лимфоциты
Под влиянием интерлейкинов -4, -5, -6, выделяющихся Т-хелперами, происходит выработка антител в большом количестве.
β-клетки определяют варианты антител, чтобы остановиться на том, который точнее всего соответствует конкретному антигену. После этого необходимые антитела производятся в достаточном количестве для уничтожения антигенов, а состав антитела вписывается в генетическую память, чтобы при следующей встрече с тем же вирусом иммунная система обладала уже испытанным и надежным оружием защиты.
Кратко остановим ваше внимание на вопросе: как обучаются лимфоциты?
Еще задолго до того, как иммунные клетки будут принимать участие в иммунном ответе, они рождаются, созревают и учатся. Преимущественное большинство иммунных клеток рождается в костном мозге, или тимусе (вилочковой железе). Клетки, произведенные в костном мозге, остаются там до полного созревания или отправляются на обучение в тимус. Обучение в вилочковой железе проходят практически все незрелые Т-клетки. До 80 % клеток, проходящих обучение в тимусе, гибнут, так и не покинув свою «школу», поскольку они не научаются отличать «своего» и «чужого».
В то же время в некоторых случаях иммунная система не различает, где «свои» и «чужие» клетки, и даже более того – начинается атака на собственные клетки. Этот процесс называется аутоиммунитетом. Такой аутоиммунный процесс разрушения собственных тканей мы можем наблюдать при некоторых формах сахарного диабета, при заболеваниях щитовидной железы (в частности, при радиационном тиреоидите), ревматическом артрите, рассеянном склерозе и др.
В других случаях иммунная система реагирует симптоматикой гиперчувствительности на встречу с невинными антигенами (пыльца цветов, некоторые пищевые продукты и др.).
Нежелательная реакция иммунной системы возникает и после пересадки органов в виде отторжения трансплантанта, т. е. реакция нашей иммунной системы на появление чужеродной ткани.
Иммунная система – весьма сложная система, обеспечивающая благополучие нашего пребывания и жизни в окружающем мире. Понятно, что иммунная система может угнетаться при заболеваниях и стрессах, при недостаточном питании и переутомлении.
Как же стимулировать иммунную систему? Что главнее в этом сложном процессе?
Специалисты-иммунологи выделяют четыре большие категории стимуляторов иммунной системы:
- Активаторы обмена информацией внутри иммунной клетки, что приводит к увеличению эффективности ее работы.
- Стимуляторы роста количества иммунных клеток, повышение их агрессивности и эффективности взаимодействия с антигеном при встрече.
- Блокирование образования свободных радикалов, которые являются одной из главных причин старения и возникновения многих болезней, особенно заболеваний сердца и мозга.
- Обеспечение физиологического состава и активности элементов крови и тканевой жидкости, т. е. жидкостей, в которых работают иммунные клетки.
Стимуляторы иммунной системы не являются лекарствами в полном понимании этого слова. Они усиливают защитные механизмы организма, а не заменяют их. Они могут за короткий срок восстановить здоровье и значительно уменьшить шансы заболеть.
Если представить, как работают стимуляторы иммунной системы, необходимо напомнить, что иммунная клетка производит и интерлейкины, и антитела, и широкий спектр токсинов, убивающих бактерии, вирусы и раковые клетки. При необходимости каждая иммунная клетка может развиваться и делиться. Для выработки новых клеток необходимы углеводы, белки, антиоксиданты, минеральные компоненты и иные не менее важные ингредиенты. Все эти вещества человек получает, употребляя пищу.
Важным элементом осуществления иммунной защиты является нормальное состояние системы связи, или оповещения, иммунных клеток. Если что-нибудь нарушает правильную передачу сигнала, иммунная клетка может оказаться неспособной полностью расправиться с «врагом» – патогенным микроорганизмом. Так, иммунная система старых людей может оказаться настолько сниженной, угнетенной, что они начинают страдать инфекционными болезнями, на которые в молодости не обращали внимания.
Иммунитет может снижаться и за счет ослабления способности делиться у иммунных клеток. Такое бывает, когда человек переносит стресс из-за утраты близких. Тогда лимфоциты просто не отвечают на присутствие патогенного фактора.
В иных случаях клетка может просто уничтожить себя. Чаще всего такое происходит в результате длительного голодания, а также от прекращения информационной связи от рецепторов к ядру. Разрушение интерлейкинов, избыточное количество жиров (как насыщенных, так и ненасыщенных) в пище может приводить к нарушению функции иммунной клетки.
Значительные изменения иммунитета наступают с возрастом. Процесс старения – это не что иное, как распад тканей и органов, происходящий на молекулярном уровне. Молекулы сохраняют стабильность до тех пор, пока не встретятся с высокоактивными окислителями, которые называют оксидантами.
Оксиданты оказывают разрушительное действие на молекулы, заставляют их терять электроны и распадаться. Чем больше молекул распалось, тем больше образуется свободных радикалов, которые приносят разрушение соседним молекулам. Так может возникнуть воспаление или деструкция тканей, даже нарушения в структуре ДНК, вызывающие рак. Именно распадающиеся молекулы являются причиной большинства заболеваний, включая раковые, сердечную недостаточность, катаракту, цирроз печени и заболевания почек, болезни Паркинсона и Альцгеймера. Признаки старения (деградация мышц и увядание кожи) также связаны с распадом молекул под воздействием окислителей.
Какие же факторы провоцируют увеличение свободных радикалов?
Их много: коротковолновое видимое и ультрафиолетовое излучение, различные виды радиоактивного излучения (особенно действие альфа-лучей), промышленное загрязнение воздуха, в том числе выхлопные газы автомобилей, двуокись серы из кислотных дождей, неумеренный прием лекарств, курение и переизбыток жиров в питании.
Предупредить старение невозможно, однако замедлить его можно, модулируя питание, включая в него вещества антиоксидантного действия.
Еще раз подчеркнем, что эмоциональные нагрузки резко могут снизить иммунитет за счет выброса многих веществ (кортизол, адреналин, энцефалины и эндорфины), которые очень тесно увязаны с реакциями иммунитета.
Нередко помочь своему организму можно, активизируя иммунитет. О том, как это осуществить, читайте на нашем сайте.
nmedik.org
Иммунные клетки — это… Что такое Иммунные клетки?
- Иммунные клетки
Лимфоциты (от лимфа и греч. kýtos — вместилище, здесь — клетка) — клетки иммунной системы, представляющие собой разновидность лейкоцитов, белых кровяных клеток. Лимфоциты — главные клетки иммунной системы, обеспечивают гуморальный иммунитет (выработка антител), клеточный иммунитет (контактное взаимодействие с клетками-жертвами), а также регулируют деятельность клеток других типов. В крови взрослого человека в норме содержится 20-35% лимфоцитов (1000-3000 кл/мкл). В то же время кровь содержит только около 2% лимфоцитов, находящихся в организме, остальные 98% находятся в тканях.
По морфологическим признакам выделяют два типов лимфоцитов: большие гранулярные лимфоциты (чаще всего ими являются NK-клетки или, значительно реже, это активно делящиеся клетки лимфоидного ряда — лимфобласты и иммунобласты) и малые лимфоциты (T и B клетки).
По функциональным признакам различают три типа лимфоцитов: B-клетки, T-клетки, NK-клетки.
- В-лимфоциты распознают чужеродные структуры (антигены) вырабатывая при этом специфические антитела (белковые молекулы, направленные против чужеродных структур).
- Т-лимфоциты выполняют функцию регуляции иммунитета. Т-помощники стимулируют выработку антител, а Т-супрессоры тормозят ее.
- NK-лимфоциты осуществляют контроль над качеством клеток организма. При этом NK-лимфоциты способны разрушать клетки, которые по своим свойствам отличаются от нормальных клеток, например, раковые клетки.
Дополнительные изображения
Рисунок, полученный с помощью сканирующего электронного микроскопа, обычной циркулирующей крови человека, содержащей красные клетки крови, несколько видов белых клеток крови, а именно: лимфоциты, моноциты и нейтрофил и много тромбоцитов в форме мелких дисков.
Источники информации
См. также
Wikimedia Foundation. 2010.
- Иммунитет организма
- Иммунодепрессант
Смотреть что такое «Иммунные клетки» в других словарях:
Иммунные привилегии — Иммунные привилегии термин, обозначающий статус некоторых частей тела, в которых появление антигена не приводит к воспалительному иммунному ответу. В норме тканевые трансплантаты отторгаются, потому что становятся объектом атаки со стороны… … Википедия
ИММУННЫЕ РЕАКЦИИ, СПЕЦИФИЧЕСКИЕ — Иммунные реакции, направленные на определенные чужеродные клетки. Система обучается распознавать белки, маркирующие чужеродные организмы, и продуцировать определенные антитела (иммуноглобулины), которые нападают и уничтожают их. Фактически… … Толковый словарь по психологии
Тучные клетки — Тучные клетки. Тучные клетки (мастоциты, лаброциты) высокоспециализированные иммунные клетки соединительной ткани позвоночных животных, аналоги базофилов крови. Участвуют в адаптивном иммунитете. Тучные клетки рассеяны по соединительной… … Википедия
Адгерентные клетки слипающиеся к липкие к — Адгерентные клетки, слипающиеся к., липкие к. * адгерэнтныя клеткі; к., што зліпаюцца; ліпкія к. * аdherent cells иммунные клетки (такие как дендрические клетки и макрофаги), обладающие свойством прилипания к стенкам чашек для культуры тканей,… … Генетика. Энциклопедический словарь
Психонейроиммунология (ПНИ) (psychoneuroimmunology) — В течение многих десятилетий значительная часть психологов верила в то, что им удалось решить вопрос об отношении души и тела придя к соглашению, что все «психические явления» могли бы быть сведены к «физическим событиям», происходящим в головном … Психологическая энциклопедия
Приобретенный иммунитет — Приобретённый иммунитет представляет собой систему высокоспециализированных клеток, расположенных по всему организму, которые специфически реагируют на чужеродный биоматериал, обрабатывая, нейтрализуя и разрушая его. Считается, что система… … Википедия
Система комплемента — … Википедия
Иммунная система — Лимфоцит, компонент иммунной системы человека. Изображение сделано сканирующим электронным микроскопом Иммунная система подсистема, существующая у позвоночных животных и объединяющая органы и ткани, которые … Википедия
Иммунная система человека — Лимфоцит, компонент иммунной системы человека. Изображение сделано сканирующим электронным микроскопом Иммунная система подсистема, существующая у большинства животных и объединяющая органы и ткани, которые защищают организм от заболеваний,… … Википедия
Виротерапия — (Вирус от лат. virus яд; др. греч. θεραπεία лечение, оздоровление, лекарство) один из видов биотерапии, при котором применяются онкотропные/онколитические вирусы. Одно из направлений онкологии Виротерапия мобилизует… … Википедия
dic.academic.ru
что это, ее органы и функции
Иммунитет человека – это состояние невосприимчивости к различным инфекционным и вообще инородным для генетического кода человека организмам и веществам. Иммунитет организма определяется состоянием его иммунной системы, которая представлена органами и клетками.
Функции иммунной системы: сохранять постоянство внутренней среды организма, сохранять невосприимчивость к различным инфекционным микроорганизмам, вирусам, паразитам, другим чужеродным агентам, способным привести к генетическим сбоям.
То есть, иммунитет человека – это когда организм не только не болеет разными инфекциями, но и не поражается опухолями, когда у человека заживают быстро раны и порезы на коже, когда в нем не поселяются различные паразиты и т.д. То есть это более широкое понятие, чем мы привыкли думать.
Органы и клетки иммунной системы
Остановимся здесь кратко, так как это сугубо медицинская информация, ненужная простому человеку.
Красный костный мозг, селезенка и тимус (или вилочковая железа) – центральные органы иммунной системы.
Лимфатические узлы и лимфоидная ткань в других органах (например, в миндалинах, в аппендиксе) – это периферические органы иммунной системы.
Запомните: миндалины и аппендикс – НЕ ненужные органы, а очень даже важные органы в организме человека.
Основная задача органов иммунной системы человека – выработка различных клеток.
Какие бывают клетки иммунной системы?
1) Т-лимфоциты. Делятся на различные клетки – Т-киллеры (убивают микроорганизмов), Т-хелперы (помогают распознавать и убивать микробов) и другие виды.
2) В-лимфоциты. Главная их задача – выработка антител. Это вещества, которые связываются с белками микроорганизмов (антигены, то есть инородные гены), инактивируют их и выводятся из организма человека, тем самым «убивая» инфекцию внутри человека.
3) Нейтрофилы. Эти клетки пожирают инородную клетку, разрушают ее, при этом также разрушаясь. В итоге появляется гнойное отделяемое. Характерный пример работы нейтрофилов – воспаленная рана на коже с гнойным отделяемым.
4) Макрофаги. Эти клетки также пожирают микробов, но сами не разрушаются, а уничтожают их в себе, либо передают на распознавание Т-хелперам.
5)Эозинофилы. Вырабатывают вещества, которые разрушают паразитов в организме человека. Характерное проявление работы эозинофилов – аллергическая реакция на гельминтов (на глисты).
Есть еще несколько клеток, которые выполняют узкоспециализированные функции. Но они интересны специалистам-ученым, а простому человеку достаточно тех видов, что указаны выше.
Виды иммунитета
1) И вот теперь, когда мы узнали, что такое иммунная система, что она состоит из центральных и периферических органов, из различных клеток, теперь мы узнаем про виды иммунитета:
- клеточный иммунитет
- гуморальный иммунитет.
Эта градация очень важна для понимания любому врачу. Так как многие лекарственные препараты действуют либо на один, либо на другой вид иммунитета.
Клеточный представлен клетками: Т-киллеры, Т-хелперы, макрофаги, нейтрофилы и т.д.
Гуморальный иммунитет представлен антителами и их источником – В-лимфоцитами.
2) Вторая классификация видов – по степени специфичности:
— неспецифический (или врожденный) – например, работа нейтрофилов в любой реакции воспаления с образованием гнойного отделяемого,
— специфический (приобретенный) – например, выработка антител к вирусу папилломы человека, или к вирусу гриппа.
3) Третья классификация – виды иммунитета, связанные с медицинской деятельностью человека:
— естественный – появившийся в результате болезни человека, например, иммунитет после ветрянки,
— искусственный – появившийся в результате прививок, то есть введения ослабленного микроорганизма в организм человека, в ответ на это в организме вырабатывается иммунитет.

Пример работы иммунитета
Теперь давайте рассмотрим практический пример, как вырабатывается иммунитет на вирус папилломы человека 3 типа, который вызывает появление юношеских бородавок. Читать статью о юношеских бородавках подробно.
В микротравму кожи (царапина, потертость) проникает вирус, постепенно проникает дальше в глубокие слои поверхностного слоя кожи. В организме человека ранее еще его не было, поэтому иммунная система человека еще не знает, как надо на него реагировать. Вирус встраивается в генный аппарат клеток кожи, и они начинают неправильно расти, принимая уродливые формы.
Таким образом формируется бородавка на коже. Но такой процесс не проходит мимо иммунной системы. Первым делом включаются Т-хелперы. Они начинают распознавать вирус, снимают с него информацию, но уничтожить его сами не могут, так как его размеры очень малы, а Т-киллер могут убить только более крупные объекты типа микробов.
Т-лимфоциты передают информацию В-лимфоцитам и те начинают выработку антител, которые проникают через кровь в клетки кожи, связываются с частичками вируса и таким образом обездвиживают их, а затем весь этот комплекс (антиген-антитело) выводится из организма.
Кроме того, Т-лимфоциты передают информацию о зараженных клетках макрофагам. Те активизируются и начинают постепенно пожирать измененные клетки кожи, уничтожая их. А на месте уничтоженных постепенно нарастают здоровые клетки кожи.
Весь процесс может занимать от нескольких недель до месяцев и даже лет. Все зависит от активности как клеточного, так и гуморального иммунитета, от активности всех его звеньев. Ведь если, например, в какой-то период времени выпадает хотя бы одно звено – В-лимфоциты, то рушится вся цепочка и вирус беспрепятственно размножается, внедряясь во все новые клетки, способствуя появлению все новых бородавок на коже.
На самом деле представленный выше пример – лишь очень слабое и очень доступное объяснение работы иммунной системы человека. Существуют сотни факторов, которые могут включать то один механизм, то другой, ускорять или замедлять иммунный ответ.
Например, иммунная реакция организма на проникновение вируса гриппа происходит намного быстрее. А все потому, что он пытается внедриться в клетки мозга, что для организма куда опаснее, чем действие папилломавируса.
Записаться на платный прием к иммунологу в Москве на ближайшее время
И еще один наглядный пример работы иммунитета — смотрим видео.
Хороший и слабый иммунитет
Тема иммунитета стала развиваться в последние 50 лет, когда были открыты многие клетки и механизмы работы всей системы. Но, к слову сказать, до сих пор открыты не все ее механизмы.
Так, например, наука пока еще не знает, каким образом запускаются те или иные аутоиммунные процессы в организме. Это когда иммунная система человека ни с того, ни с сего начинает воспринимать собственные клетки как чужеродные и начинает с ними бороться. Это как в 37-м году – НКВД начало бороться против собственных граждан и поубивало сотни тысяч людей.
В целом же надо знать, что хороший иммунитет – это состояние полной невосприимчивости к различным инородным агентам. Внешне это проявляется отсутствием инфекционных заболеваний, здоровьем человека. Внутренне это проявляется полной работоспособностью всех звеньев клеточного и гуморального звена.
Слабый иммунитет – это состояние восприимчивости к инфекционным заболеваниям. Проявляется слабой реакцией того или иного звена, выпадением отдельных звеньев, неработоспособностью тех или иных клеток. Причин его снижения может быть довольно много. Следовательно, и лечить его надо, устраняя все возможные причины. Но об этом поговорим в другом материале.
Рекомендую также прочесть эти материалы:
www.dermatologvenerolog.ru